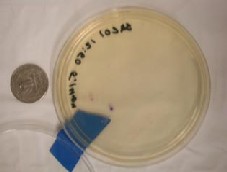

The E.coli membrane filtration method most easily available for field use uses a medium developed and marketed by the Hach Co called m-ColiBlue24 that tests for total coliforms and E.coli simultaneously. The kit is the same as the one described for fecal coliforms except for the culture medium. The incubation temperature is also different (35C for E.coli).
The Hach Co. website has a library of documentation about how to conduct the procedure and what can go wrong.
We have results from two sample sets that are large enough to compare results for different processing locations. Each sample set consisted of 5 field replicates, 5 done a few hours later using the kit on the truck, 5 processed in the SDTDC water lab (‘lab’ in the plot below), and 5 done by the certified lab (‘CP’).
Haiganoush Preisler, statistician with the PSW Research Station in Albany, CA analyzed and interpreted the data. Results are shown in the notched box plots below. In these plots, the two sets processed outside using the kit have been combined (‘FT’) because the results did not differ substantially. Each box represents the middle 50% of the data and the middle line inside the box is the median for that set of data. (For example, the median of the square root of the counts for the field data is 2.1). The rest of the data are between the extended bars. Outliers are shown as ‘o’. Where the notches do not overlap, there is strong evidence that the medians of the data sets are different. These results indicate that there is a small but significant difference between the sample sets run by the SDTDC tester and those run at the laboratory, with the laboratory getting higher numbers. With these sample sets, the numbers of E.coli were so low that the difference would not matter for regulatory reporting purposes. Distinguishing the cause (and verifying the reality) of the discrepancy would require much more testing.
Figure 9. Comparing E.coli counts conducted at different
locations. All were processed within the 8-hr holding time.
E. coli colonies are blue on the m-Coliblue medium, and other bacteria in the coliform group (total coliforms) form red colonies (Figure 10)
Figure 10. Typical E. coli filter on m-Coliblue growth medium.
Figure 11. m-Coliblue filter with E. coli from sediment-laden water sample.
The E. coli test does not require the incubator to maintain quite as stable a temperature as the fecal coliform test does (+ 0.5C rather than +0.2C) so the Hach incubator is adequate. See test results for incubators.
The kit we recommend for E.coli uses processing materials and hardware provided by the IDEXX company. The test uses the medium Colilert (ONPG-MUG) which fluoresces when it reacts with an enzyme produced by E.coli.
Figure 12 shows some of the components for the test. Moving counterclockwise from right, they are: a) the dry medium (here, Colilert(tm)) which is mixed with the sample, b) the sample collection bottle, c) the box the medium comes in, and d) the multi-welled Quanti-Tray(tm). The rubber tray in the center (e) holds the Quanti-Tray as it is inserted into the sealer, shown in Figure 13.
Figure 12. Quanti-Tray, Snap-pak with
Colilert medium, sample bottle and rubber insert
for passing Quanti-Trays through sealer.
Figure 13. IDEXX sealer
The results are reported as the most probable number/100mL (MPN/100mL) with set confidence limits. The test does not count individual colonies, as in the membrane filtration test. Instead it counts the number of wells that show evidence of the enzyme produced by E.coli. See Standard Methods Part 9223 A and B for more discussion of the method. IDEXX also has packets of detailed information and a training video.
The Quanti-Tray pictured in Figure 14 counts up to 200 cfu/100 mL. The Quanti-Tray 2000 can count up to more than 2400 cfu/100 mL. Either tray can be used with Colilert media that take either 24 or 18 hours of incubation.
Figure 14. a) Yellow color under ordinary light indicates total coliform presence. b) Fluorescent wells indicate E.coli.
The Colilert method enumerates both total coliforms, which are indicated by yellow wells, and E.coli, which are fluorescent wells. In Figure 14a, all wells, including the large overflow well at the top, are counted to determine the total coliform count. The sample has more than 200 cfu/100 mL of total coliforms and the counting range has been exceeded. (This is nearly always the case in natural waters). The fluorescence generated by E.coli shows up under a black light (366 nm wavelength) in Figure 14b. According to the MPN table provided with the Quanti-Trays, the 8 fluorescent wells would be reported as a MPN 8.7 cfu/100 mL with 95% confidence limits of 4.5 to 17.1.
Results of multiple well enzyme substrate testing for E.coli
Field vs laboratory results
For the multi-well enzyme substrate method, split samples processed in the field and at the SDTDC water lab gave very similar results. The single sample set we have with data from a certified lab also shows very similar results. Table 3 shows the average MPN/100mL for 5 split samples processed at different locations in four sampling events. Repeatability for different processing locations is clearly good. The different results we encountered with membrane filtration tests done at different times (but always within the 8 hour holding time) did not occur with the IDEXX E.coli procedure. We have too little data to compare field to certified lab results, but with such a self-contained procedure there seems little reason to expect disparities.
Table 3. Most Probable Number of E.coli using Colilert procedure
Processing location |
Field |
Truck (1-3 hours later than field) |
SDTDC water lab |
Certified lab |
| Date |
|
| 6/30/04 |
|
43 |
46 |
|
| 7/6/04 |
62 |
53 |
58 |
|
| 7/704 |
|
150 |
150 |
|
| 7/27/04 |
0.4 |
|
|
0.4 |
The reason we do not have more validation data from the certified lab is that at first our contract lab used the multiple tube fermentation (MTF) technique for total coliforms, fecals and E.coli. This MPN technique has a broad 95% confidence band, and it was not infrequent to receive reports showing the same MPN for total, fecal and E.coli. The one time the lab used the Quanti-tray method, their results and ours were essentially the same. In setting up your QA/QC plan, you will need to ensure your certified lab uses a valid method of analysis that permits comparison between field and lab results.
Comments on the E.coli multiwell enzyme substrate test
Cost- This is a simple, self-contained method. It has the highest startup costs, but disposables cost only slightly more than for membrane filtration ($5.60/sample) , and processing and analysis time is shorter. The SDTDC tester was able to process ten or more samples in fifteen minutes, and read the results following incubation in five. If sampling events will be few and far between, the equipment for this kit may be prohibitively expensive; however, if you will use it a lot, it will probably be worth it.
Durability of components- The sealer is not designed for the field, and would require a technician to repair. However, it is surprisingly rugged. It survived the typical bumps and shaking of being moved around in the truck with no problem. It also survived being shoved into a particularly ill-fitted slot in an early prototype of the kit and yanked free, with only a few loose screws. Users would be well advised to treat the unit with care; however, it should survive most minor accidents.
As an added bonus, the Colilert medium used for this test does not spoil in all but the most extreme temperature conditions, eliminating the need for refrigeration.
The Snap-Paks, which contain the dry medium, should be opened with the narrow end facing up, rather than down as shown in the video. If medium is collected around the snap point, the force of the break will scatter some of the medium over the working surface; it will not, in fact, all fall neatly into the sample bottle.
Another issue to be aware of is the durability of the Quanti-Trays themselves. Unless subjected to moderate pressure, such as stepping on them, the plastic wells themselves will hold up; however, when sealed, the backing can tear if it is scraped against an abrasive surface.
Ideally, the incubator for this kit should be larger than the Hach or Millipore field incubators, since the Quanti-Trays do not fit easily into their small chambers. The Millipore incubator holds only 4 slightly rolled Quanti-Trays, and the Hach can hold six. The larger incubator we tested can hold over 50 trays flat. However, it is not designed for the field, and in limited testing it appeared to have poorer temperature stability when used with a 12V battery and inverter. See incubators for more information.
Performance- This method does not appear to be affected by stressed bacteria or turbidity. There is no uncertainty about which color colonies to count, as there frequently is when counting colonies grown on M-FC or Coliblue media. Because of the larger number of wells, the Quanti-Trays produce most probable numbers with narrower confidence bands than the common multiple tube fermentation method using15 tubes. Precision is comparable to that of membrane filtration for fairly low densities (say, less than 60 cfu/100 mL). The confidence bands widen as the density estimate increases. See Standard Methods section 9222B (APHA 1998) for membrane filtration confidence limits.
Portability/ease of use in the field- Less time (combined) is spent processing samples and analyzing results than any other method. Results are easily interpreted and rarely ambiguous. While the user must take care that the dry medium does not blow away in the wind, none of our tests showed any effect of dust blown into the sample during processing. Waste is fairly minimal, and does not need special treatment prior to disposal.
The E.coli multiwell enzyme substrate kit
The kit box is 24.25” deep by 60.25” wide and 16.25” high. ¾” plywood is used for the box and interior dividers that form the spaces for the sealer, inverter, incubator, Quanti-Tray and Colilert storage, the blacklight, and any other instruments (Figure 15). A tray for the 12V marine battery is attached (left side of photo), and there is a V-slot to bring the battery cable into the box for power. The photo shows the kit with the Millipore incubator. The box should be fully lined with insulating and cushioning foam.

Figure 15. An early version of the kit using the IDEXX system
for E.coli enumeration, without full foam lining.
Figure 16. The E.coli (multiwell enzyme substrate test)
kit box design
a) plan view (looking down)
b) front view
The inverter converts 12V DC power from the marine battery or the vehicle battery to 115V AC power for the sealer. This application requires a 1500W or larger inverter, and it must run off a deep cycle battery. The sealer draws nearly 60 amps—possibly more during warm-up--which could blow the vehicle lighter or power port fuse (commonly 20A). A single fully charged 120 amp-hour deep cycle battery would be expected to support the sealer for two separate sampling events (that is, where the sealer is warmed up twice).
Any of the incubators we tested could run off the vehicle battery. If you use the Lab-line incubator, an inverter would be needed. More details on powering the equipment are in Batteries and Inverters.
Here is the list of kit components. All prices were as of 2004.
Reusable:
[Components from IDEXX are in italics. The IDEXX system with supplies for 200 tests was $3210.]
Sealer -- $3050
Rubber insert for sealer -- $60
Quanti-Tray comparator (to check color of positive wells) -- $6
Quanti-Tray interpretation charts (MPN)
UV light, rechargeable: $119
Inverter: We used a 750W Whistler inverter, $130 from Ben Meadows.
[Note the inverter must have enough wattage to power the sealer (115V x 6 amps = 690 watts continuous load, higher start-up load. It must also support the 58 amps the sealer will draw from a 12V battery. Use an inverter with 1500W or higher capacity.]
Incubator: Millipore, $2159.
Lab-line 120, $376 from Barnstead International, Dubuque IA
Spare fuses for sealer, incubator, and inverter
3 marine deep cycle batteries:@ $70
Thermometer
Bucket, with rope for drops
Cooler, unless all samples are processed on site
Felt-tipped, waterproof, rub-proof marking pen
Disposables:
Quanti-Trays: 51-well (for up to 200 cfu/100mL) @$85/100. Q-T2000 (for up to 2000 cfu/q00mL) are $125/100
Snap-paks with Colilert or Colilert-18 medium @ $850/200
Sample bottles -- $100/200
Ice, unless all samples are processed on site.
Wipe/liquid/etc. for disinfecting working surface
Coliscan Easygel
Easygel is not federally approved for coliform analysis in recreational waters (although it is approved for drinking water). However, at least two states (Indiana and Alabama) have approved it. Sample processing is easy, and supposedly the medium can be incubated at room temperature (but see below). It is both the least expensive method and the least demanding in terms of space that we tested.
The procedure is as follows. The tester pipettes a measured volume of sample (maximum 5 ml) directly into a bottle of medium. The bottle is swirled to mix the two; then emptied into a petri dish treated with a special compound. Once poured, medium interacts with the compound, and solidifies over approximately 1 hour. It may then be incubated for 24 hours at 35o C, or, according to the company literature, for 48 hours at room temperature. E. coli colonies are typically purplish blue, while other coliforms are purplish red. Figure 17 shows a dish photographed with a quarter for scale.
Figure 17. Petri dish with a single E. coli colony on Easygel medium.
Our testing was not extensive, but the results we did get were somewhat unsatisfactory.
- The maximum sample volume that can be tested with Easygel is only 5 ml. Unless the water sample has high densities of E.coli, a 5 mL sample will not give accurate or repeatable counts (see table easygel).
- Unlike membrane filtration, colonies grow throughout the medium, rather than just at the surface. As the medium itself is yellow, this can make color distinction more difficult.
- After the medium is poured into the petri dishes, it must be left undisturbed for at least 45 minutes to set; typically, we had to hold the dishes for over an hour before they had completely solidified.
- Air bubbles present in the liquid can become trapped prior to solidification, and are approximately the same size as the average coliform colony.
- No grid is provided on the somewhat larger (than membrane filtration) dishes, making counts of heavily populated plates difficult.
Results for sample splits from a single water sample are shown below. Some splits were plated in the field at the sample site, some on the truck several hours later, and the last set were plated and incubated in the SDTDC water lab. All results should be identical. Part of the large variability is caused by multiplying the actual count by 20 to present results in standard units.
Although these data are inadequate to support a solid conclusion, there is a suggestion that incubating the plates at room temperature was not sufficient. The median number of colonies for the incubated samples processed in the field and on the truck was 4 (100/100mL), but only 1 (20/100mL) for the samples held at room temperature.
Alabama Water Watch uses Easygel, and their bacteriological quality assurance plan is posted on their website. Easygel is also approved for some uses in Indiana, and it is used by the Indiana Hoosier River Watch Program. Both groups have much more experience with Easygel than is reflected in this report, and if you are testing water with high densities of E.coli, you may want to look at their material.
Table 5. E.coli/100mL for a single water sample. Splits were processed
at different locations & incubated at different temperatures
| |
| |
incubated at 35C |
ambient temperature |
| Field |
140 |
40 |
| Field |
100 |
60 |
| Field |
80 |
20 |
| Field |
140 |
120 |
| Field |
80 |
60 |
| Truck |
20 |
20 |
| Truck |
0 |
20 |
| Truck |
80 |
20 |
| Truck |
0 |
0 |
| Truck |
80 |
20 |
| Lab |
240 |
|
| Lab |
100 |
|
| Lab |
100 |
|
| Lab |
200 |
|
| Lab |
100 |
|